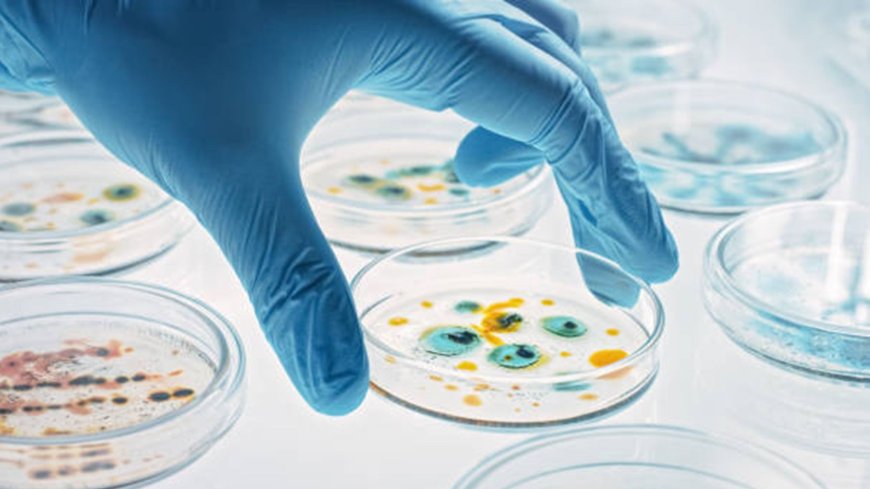
The Impact of Healthcare Technology Solutions on Global Health Trends

The Impact of Healthcare Technology Solutions on Global Health Trends
Healthcare is changing faster than ever. New tools and technologies are not just making treatments easier; they’re changing how we understand diseases and keep people healthy around the world.
Healthcare is changing faster than ever. New tools and technologies are not just making treatments easier; they’re changing how we understand diseases and keep people healthy around the world. From tracking outbreaks to personalizing care, Healthcare Technology Solutions are at the center of this shift. This article will explain how these tools are shaping global health, the challenges that remain, and the latest research guiding modern medicine.
How Technology Improves Healthcare
Technology is now part of almost every healthcare system. Tools like electronic health records, telemedicine, wearable devices, and AI-powered diagnostic systems are examples of Healthcare Technology Solutions that help doctors and patients alike.
For example, telemedicine lets patients in rural areas consult specialists online, saving travel time and money. AI can quickly analyze large amounts of data, spotting patterns humans might miss. This helps detect diseases like diabetes, cancer, and heart problems earlier, which can save lives.
Wearables like smartwatches can track heart rate, sleep patterns, and even oxygen levels. Apps can remind patients to take their medicine or track symptoms over time. These small tools make a big difference in keeping people healthy.
Challenges Facing Public Health
Even with advanced technology, there are still major Challenges Facing Public Health. Not all communities have equal access to tech, especially in low-income countries. Privacy and data security are also concerns since patient information is shared online.
The world’s population is growing and aging, which increases the demand for hospitals, doctors, and medications. Technology helps ease this pressure by automating tasks, tracking supplies, and supporting health campaigns. For instance, digital tools can track vaccinations, predict disease outbreaks, and map how illnesses spread. This helps health authorities act faster and smarter.
Microbiology Research Trends
Research in microbiology is changing thanks to technology. Microbiology Research Trends focus on understanding viruses, bacteria, and other pathogens. New lab equipment and AI-driven analysis help scientists study these tiny organisms faster and more accurately.
For example, AI can analyze genetic sequences of viruses to speed up vaccine development. Researchers can also model disease outbreaks virtually, testing treatments without waiting months for lab experiments. These advances make healthcare systems stronger and better prepared for health crises.
The Future of Global Health
Life Science News shows how technology is shaping the future of healthcare. Wearables and apps are becoming more common. They allow people to monitor their health in real-time and communicate directly with doctors.
Global health trends are moving toward preventive care, personalized medicine, and decisions based on data. Countries investing in healthcare technology are seeing lower death rates and healthier populations. Even small innovations, like AI diagnostic apps, can have a big impact when used around the world.
Important NOTE!
Healthcare technology is more than a convenience; it is essential. Healthcare Technology Solutions are changing patient care, tackling Challenges Facing Public Health, and driving Microbiology Research Trends. By embracing these tools, the world can create healthier communities, respond faster to outbreaks, and improve the quality of life for everyone!































